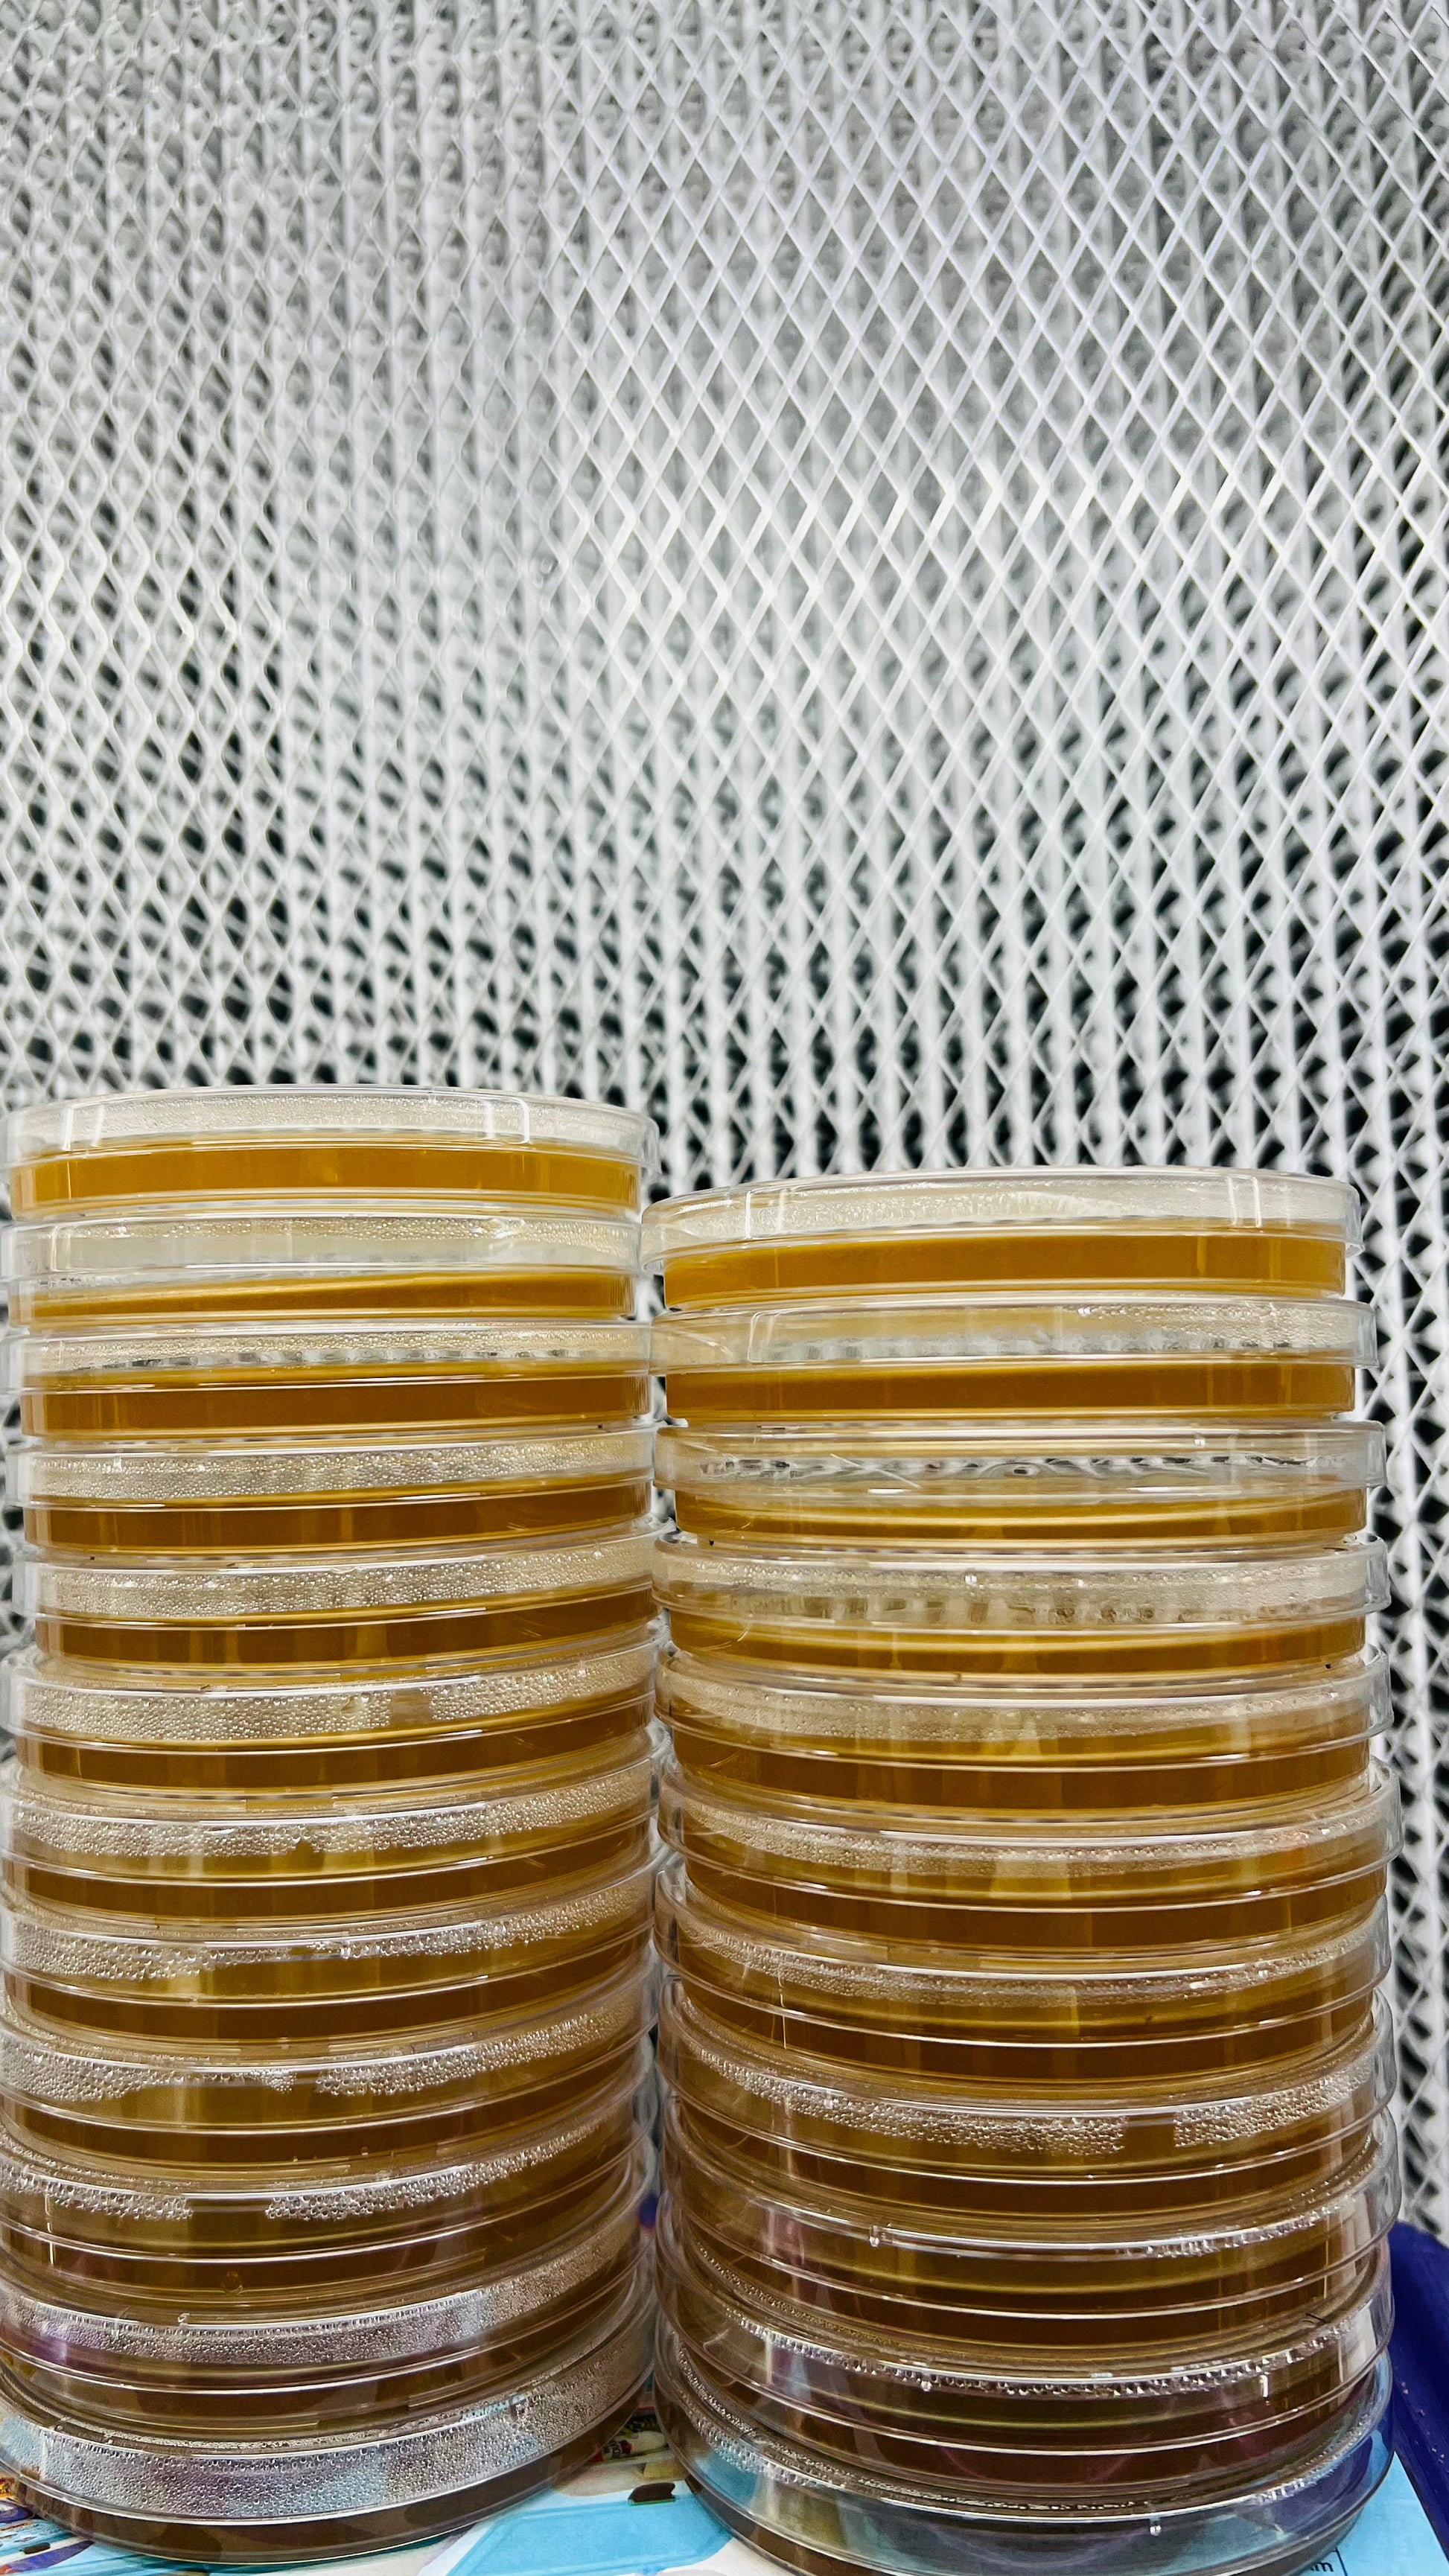

Set of five Potato dextrose agar Petri plates.
It comes in a reusable PP plates.
Sterilized in a hospital-grade horizontal sterilizer.
Includes 5 Parafilms.
All the plates are made to order.
What are Prepoured Agarplates?
Prepoured agarplates are essential tools in microbiology labs because they provide a sterile medium for the growth of microorganisms. They consist of agar gel that is already prepared and poured into petri dishes, which saves researchers time and ensures consistency. These plates are pre-sterilized, meaning they are ready to use right out of the package, reducing the risk of contamination during preparation.
Applications of Prepoured Agarplates
Scientists and researchers use prepoured agarplates for diverse applications, including isolating and identifying bacteria, fungi, and yeast. They are particularly useful in clinical microbiology to ensure accurate diagnosis of infectious diseases. Furthermore, prepoured plates are invaluable in educational settings, as they allow students to observe microbial growth without needing extensive laboratory skills. This accessibility enhances learning and fosters interest in the sciences.
Benefits of Using Prepoured Agarplates
One of the major benefits of using prepoured agarplates is convenience; they eliminate the need for time-consuming lab preparation. However, their consistency in formulation means that experiments can be replicated more easily, which is critical for scientific validity. Additionally, these plates often come in various types, such as nutrient agar or selective media, tailored to specific organisms, making them versatile tools in any laboratory setting.
Understanding Prepoured Agarplates
Prepoured agarplates are specialized laboratory dishes that contain agar gel, a substance derived from seaweed, used as a growth medium for microbiological cultures. These plates are ready to use, eliminating the need for preparation by the user. They are usually sterilized and sealed to keep them free from contamination, making them ideal for both professional microbiologists and students who are just starting in the field.
The Importance of Using Prepoured Agarplates
Using prepoured agarplates provides several advantages. First, they save time because you don’t have to prepare the agar yourself. This is especially beneficial in fast-paced laboratory environments. Additionally, they ensure consistency since the agar is premeasured and mixed, which leads to reliable experimental results. Therefore, selecting the right type of agar plate becomes crucial for your experimental needs.
Types of Prepoured Agarplates
There are various types of prepoured agarplates available to cater to different needs. For instance, standardnutrient agar is commonly used for routine microbiological work, while selective media like MacConkey agar are suitable for isolating specific bacteria. Because each type serves a unique purpose, understanding which one to use can significantly improve the success of your culturing efforts. So, it is important to choose the right preliminarily prepared agarplates that align with your specific experiments.
Understanding Prepoured Agarplates
Prepoured agarplates are specialized laboratory dishes that contain agar gel, a substance derived from seaweed, used as a growth medium for microbiological cultures. These plates are ready to use, eliminating the need for preparation by the user. They are usually sterilized and sealed to keep them free from contamination, making them ideal for both professional microbiologists and students who are just starting in the field.
The Importance of Using Prepoured Agarplates
Using prepoured agarplates provides several advantages. First, they save time because you don’t have to prepare the agar yourself. This is especially beneficial in fast-paced laboratory environments. Additionally, they ensure consistency since the agar is premeasured and mixed, which leads to reliable experimental results. Therefore, selecting the right type of agar plate becomes crucial for your experimental needs.
Types of Prepoured Agarplates
There are various types of prepoured agarplates available to cater to different needs. For instance, standardnutrient agar is commonly used for routine microbiological work, while selective media like MacConkey agar are suitable for isolating specific bacteria. Because each type serves a unique purpose, understanding which one to use can significantly improve the success of your culturing efforts. So, it is important to choose the right preliminarily prepared agarplates that align with your specific experiments.